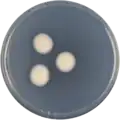
Aspergillus luppii growing on CYA plate

Aspergillus luppii
| Aspergillus luppii | |
|---|---|
| Scientific classification | |
| Kingdom: | Fungi |
| Division: | Ascomycota |
| Class: | Eurotiomycetes |
| Order: | Eurotiales |
| Family: | Aspergillaceae |
| Genus: | Aspergillus |
| Species: | A. luppii
|
| Binomial name | |
| Aspergillus luppii | |
| Type strain | |
| CBS 653.74, CCF 4545, NRRL 6326, NRRL MOLD 6326, PRM 923447[2] | |
| Synonyms | |
|
Aspergillus aureofulgens | |
Aspergillus luppii (also called A. aureofulgens) is a species of fungus in the genus Aspergillus.[1][2][3] It is from the Flavipedes section.[4] Aspergillus luppii produces the antimicrobics Curvularin and Dehydrocurvularin.[5][6]
Growth and morphology
A. luppii has been cultivated on both Czapek yeast extract agar (CYA) plates and Malt Extract Agar Oxoid® (MEAOX) plates. The growth morphology of the colonies can be seen in the pictures below.
-
Aspergillus luppii growing on CYA plate
Aspergillus luppii growing on CYA plate -
 Aspergillus luppii growing on MEAOX plate
Aspergillus luppii growing on MEAOX plate
References
- ^ a b "Aspergillus aureofulgens". www.mycobank.org.
- ^ a b c "Aspergillus luppii". www.uniprot.org.
- ^ "A. aureofulgens | Aspergillus & Aspergillosis Website". www.aspergillus.org.uk.
- ^ Hubka, Vit; Nováková, Alena; Kolarik, Miroslav; Jurjevic, Zeljko; Peterson, Stephen W. (2015). "Revision of Aspergillus section Flavipedes: seven new species and proposal of section Jani sect. nov". Mycologia. 107 (1): 169–208. doi:10.3852/14-059. PMID 25344259.
- ^ Fugmann, Burkhard; Lang-Fugmann, Susanne; Steglich, Wolfgang (2014). RÖMPP Encyclopedia Natural Products, 1st Edition, 2000. Georg Thieme Verlag. ISBN 9783131795519.
- ^ Betina, V. (1993). Chromatography of Mycotoxins: Techniques and Applications. Elsevier. ISBN 9780080858623.
Further reading
- Caputo, O.; Viola, F. (1977). "Isolation of a, beta-dehydrocurvularin from Aspergillus aureofulgens". Planta Medica. 31 (1): 31–32. doi:10.1055/s-0028-1097485. ISSN 0032-0943. PMID 840925.
- Gesellschaft für Arzneipflanzenforschung (Germany), Deutsche Gesellschaft für Arzneipflanzenforschung (1977). Planta medica. Hippokrates-Verlag.
- Laskin, Allen I.; Lechevalier, Hubert A. (1988). CRC Handbook of Microbiology: pt. A. Antibiotics. Chemical Rubber Company.